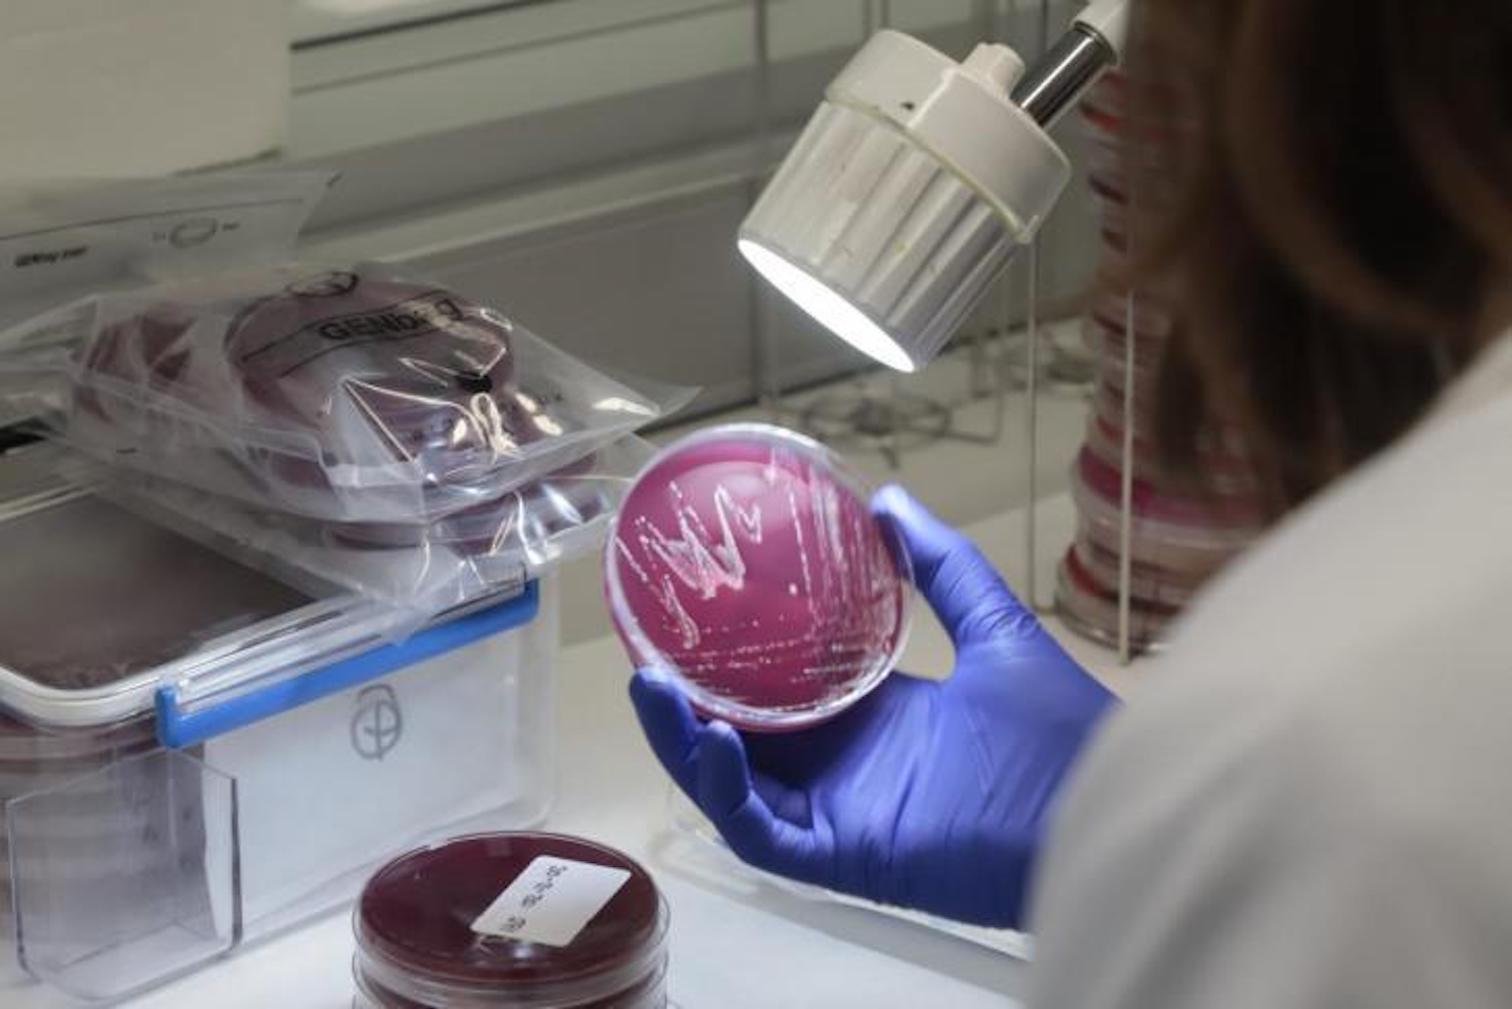

By Majorca Daily Bulletin reporter
The first two cases of the Delta Plus variant of Covid-19 have been confirmed in the Balearic Islands.
The Microbial Genomics Unit at Son Espases University Hospital discovered two cases of AY.4.2 during random testing of around 90 samples taken in the Balearic Islands between November 1 and 7, 2021.
53 cases of Delta Plus have been confirmed via sequencing nationwide and 11 of them were from random sampling, according to the Centre for the Coordination of Emergencies & Health Alerts.
The Conselleria de Salut i Consum says that although this new subvariant is 10-15% more contagious it does not appear to be more aggressive than the standard Delta variant that’s present in the Balearics and it's not more resistance to the Covid vaccines.
The Microbiology Laboratory at Son Espases Hospital will continue with genomic sequencing studies to follow the evolution and surveillance of the coronavirus pandemic in the Balearic Islands.
November 17, 2021 at 01:41PM
via Majorca Daily Bulletin News Feed read more...

0 Comentarios